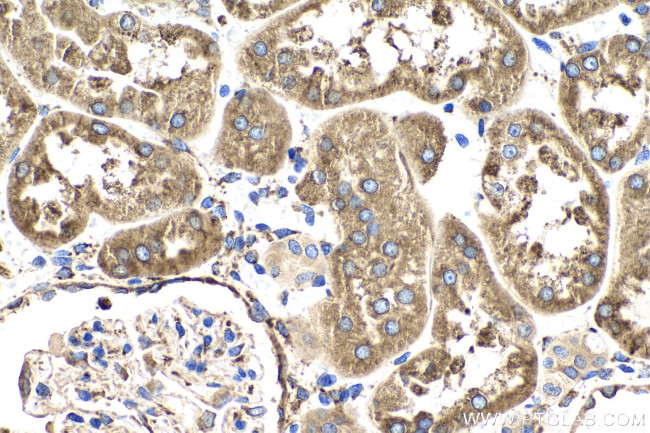
LRPAP1 Antibody in Immunohistochemistry (Paraffin) (IHC (P))
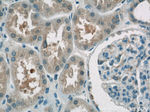
LRPAP1 Antibody in Immunohistochemistry (Paraffin) (IHC (P))

Search
Proteintech
LRPAP1 Polyclonal Antibody
{{$productOrderCtrl.translations['antibody.pdp.commerceCard.promotion.promotions']}}
{{$productOrderCtrl.translations['antibody.pdp.commerceCard.promotion.viewpromo']}}
{{$productOrderCtrl.translations['antibody.pdp.commerceCard.promotion.promocode']}}: {{promo.promoCode}} {{promo.promoTitle}} {{promo.promoDescription}}. {{$productOrderCtrl.translations['antibody.pdp.commerceCard.promotion.learnmore']}}
产品信息
24662-1-AP
种属反应
宿主/亚型
分类
类型
抗原
偶联物
形式
浓度
规格
纯化类型
保存液
内含物
保存条件
运输条件
产品详细信息
Immunogen sequence: YSREKNQPK PSPKRESGEE FRMEKLNQLW EKAQRLHLPP VRLAELHADL KIQERDELAW KKLKLDGLDE DGEKEARLIR NLNVILAKYG LDGKKDARQV TSNSLSGTQE DGLDDPRLEK LWHKAKTSGK FSGEELDKLW REFLHHKEKV HEYNVLLETL SRTEEIHENV ISPSDLSDIK GSVLHSRHTE LKEKLRSINQ GLDRLRRVSH QGYSTEAEFE EPRVIDLWDL AQSANLTDKE LEAFREELKH FEAKIEKHNH YQKQLEIAHE KLRHAESVGD GERVSRSREK HALLEGRTKE LGYTVKKHLQ DLSGRISRAR HNEL (35-357 aa encoded by BC112067)
靶标信息
The term RAP typically refers to receptor-associated protein, encoded by the LRPAP1 gene, which plays a significant role in the trafficking and function of certain receptors within cells. RAP is primarily involved in the regulation of low-density lipoprotein receptor-related proteins (LRPs) by acting as a chaperone during protein transport within the endoplasmic reticulum (ER). It prevents premature ligand binding and assists in the proper folding and assembly of receptor complexes, ensuring efficient receptor function and trafficking to the cell surface. RAP also influences cellular processes related to cholesterol metabolism and cell signaling through its interactions with these receptors. Its function is crucial for transporting and recycling receptors involved in various pathways, including lipid metabolism, endocytosis, and cellular homeostasis. Dysregulation of RAP or related receptor functions can impact metabolic health and are implicated in conditions such as atherosclerosis, neurodegenerative disorders, and cancer.
仅用于科研。不用于诊断过程。未经明确授权不得转售。
生物信息学
蛋白别名: 39 kDa receptor-associated protein; Alpha-2-macroglobulin receptor-associated protein; Alpha-2-MRAP; low density lipoprotein receptor-related protein associated protein 1; Low density lipoprotein receptor-related protein-associated protein 1; low density lipoprotein-related protein-associated protein 1 (alpha-2-macroglobulin receptor-associated protein 1); RAP; unnamed protein product
基因别名: A2MRAP; A2RAP; alpha-2-MRAP; HBP44; LRPAP1; MRAP; MYP23; RAP
UniProt ID: (Human) P30533
Entrez Gene ID: (Human) 4043